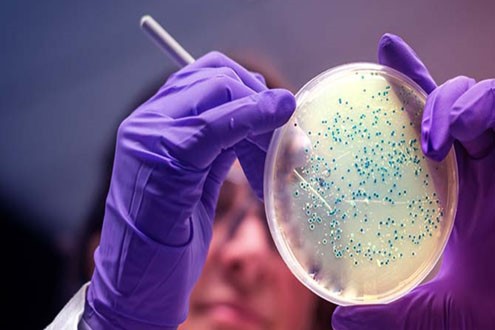
5-Amino-1MQ Cost | Shaanxi BLOOM Tech Co., Ltd 5-Amino-1MQ Cost | Shaanxi BLOOM Tech Co., Ltd

The5 amino 1 mq peptidli in'ektsiyatadqiqotchilar orasida katta qiziqish uyg'otdi, chunki u metabolik testlarda qo'llanilishi mumkin. Olimlar uning metabolik yo'llarga qanday ta'sir qilishini va nikotinamid N-metiltransferaza (NNMT) blokirovkasini o'rganar ekan, ular uni qanday qilib to'g'ri ishlatishni bilishlari juda muhimdir. Ushbu batafsil qo'llanmada 5 ta Amino 1MQ in'ektsiyasini qanday tayyorlash, berish va tajriba usullariga kiritish haqida batafsil ma'lumot beriladi. Bu tadqiqotchilar va laboratoriyalar uchun juda foydali bo'ladi.

5-amino-1MQ peptid in'ektsiyasi
1. Umumiy spetsifikatsiya (stokda)
(1) API (sof kukun)
(2) Planshetlar
(3) In'ektsiya
(4) Kapsulalar
(5) Suyuqlik
2. Moslashtirish:
Biz faqat ilm-fanni tadqiq qilish uchun OEM / ODM, brendsiz muzokaralar olib boramiz.
Ichki kod: KP-3-5/002
Asosiy bozor: AQSh, Avstraliya, Braziliya, Yaponiya, Germaniya, Indoneziya, Buyuk Britaniya, Yangi Zelandiya, Kanada va boshqalar.
NNMTi CAS 42464-96-0
Tahlil: HPLC, LC-MS, HNMR
Texnologiyani qo'llab-quvvatlash: R&D Dept.-4
ta'minlaymiz5-amino-1MQ peptid in'ektsiyasi, batafsil spetsifikatsiyalar va mahsulot ma'lumotlari uchun quyidagi veb-saytga qarang.
Mahsulot:www.kpeptide.com/peptides-sog‘lom/5-amino-1mq-peptide-injection.html
5 amino 1MQ in'ektsiyasi tadqiqot uchun qanday tayyorlanishi kerak?
Tadqiqot natijalari to'g'ri bo'lishi va qayta ishlatilishi uchun 5 Amino 1MQ zarbasi to'g'ri qilinganligiga ishonch hosil qilish muhimdir. Ushbu materialni tayyorlashning eng yaxshi usullari quyida ko'rsatilgan:
Steril filtrlash
Olingan 5 Amino 1MQ eritmasi tirik mavjudotlar yoki hujayra madaniyatlari ustida sinovlarda qo'llanilishidan oldin tozalanishi juda muhimdir. Bu 0,22 mkm filtr uchun materialni toza saqlagan holda iflosliklardan xalos bo'lishi mumkin. Bu sinov ob'ektlarida hech qanday istalmagan biologik reaktsiyalar bo'lmasligiga ishonch hosil qilish uchun juda muhim qadamdir va zarba toza bo'lib qoladi.

Qayta qurish va saqlash
Liyofillangan 5 Amino 1MQ bilan ishlashda birinchi va eng muhim narsa uni yana bir-biriga aralashtirishdir. Toza suv yoki to'g'ri tampon eritmasini kukun bilan aralashtirish kerak. Tuproqning tuzilishini himoya qilish va jarayonni ifloslantirmaslik uchun uni toza tarzda bajarish kerak.
U tuzatilgandan so'ng, eritmani xavfsiz saqlash uchun -20 daraja yoki undan past haroratda saqlanishi kerak. Kimyoviy moddalar vaqt o'tishi bilan muzlaganda va eritilganda parchalanishi mumkin. Ushbu jarayonlarni qisqartirishning bir usuli - qayta tiklangan eritmani kichikroq miqdorda qo'yishdir.

Konsentratsiya va tozalikni tekshirish
Tayyorlangan 5 Amino 1MQ in'ektsiyasi toza va to'g'ri konsentratsiyaga ega ekanligiga ishonch hosil qilish uchun uni avval sinovlarda qo'llash kerak. Olingan eritma qanchalik toza va konsentrlanganligini tekshirish uchun siz massa spektrometriyasi yoki yuqori samarali suyuqlik xromatografiyasidan (HPLC) foydalanishingiz mumkin. Ushbu qadam tufayli keyingi safar to'g'ri miqdor beriladi.
Laboratoriya tadqiqotlari uchun optimal boshqaruv usullari
Tadqiqotlarda 5 Amino 1MQ in'ektsiyasining samaradorligi uning qanday berilishiga qarab juda farq qiladi. O'zlarining eksperimental usullarini yaxshilash uchun tadqiqotchilar quyidagi eng yaxshi amaliyotlar haqida o'ylashlari kerak:

Dozaj va chastota
ning eng yaxshi miqdori va muntazamligini topish5 amino 1 mq peptidli in'ektsiyatadqiqotchilar istagan natijalarni olish uchun zarur. Qo'llaniladigan hayvon modeli yoki hujayra madaniyati usuliga asoslangan dozalarni diqqat bilan aniqlash muhimdir. Tadqiqot maqsadlariga eng mos keladigan kontsentratsiyani topish uchun doza{2}}javob testlarini o'tkazish tavsiya etiladi.
Murakkabning farmakokinetikasi va tadqiqotning davomiyligi uni qanchalik tez-tez berish kerakligini hal qilish uchun ishlatilishi kerak. O'tkir tadqiqotlar uchun bitta doz etarli bo'lishi mumkin, ammo surunkali yoki uzoq{1}}muddatli tadqiqotlar uchun bir xil miqdorni bir necha marta berish kerak bo'lishi mumkin.
Boshqaruv muddati
5 Amino 1MQ kiritilganda tajriba natijalariga katta ta'sir ko'rsatishi mumkin. Tadqiqotchilar tadqiqot ob'ektlarining sirkadiyalik ritmlari, qachon ovqatlanishlari va ular tekshiradigan biokimyoviy jarayonlar haqida o'ylashlari kerak. Variantlarni kamaytirish va takrorlanishi mumkin bo'lgan natijalarni olish uchun vaqt barcha o'quv guruhlarida bir xil bo'lishi kerak.


Boshqaruv yo'nalishi
5 Amino 1MQ ni yuborish usuli uning bioavailability va qanchalik yaxshi ishlashiga katta ta'sir ko'rsatishi mumkin. Qorin bo'shlig'iga (IP), teri ostiga (SC) va tomir ichiga (IV) in'ektsiyalar preparatni berishning keng tarqalgan usullaridir. Har bir marshrut o'zining ijobiy va salbiy tomonlariga ega:
1. Intraperitoneal (IP) in'ektsiya: Bu usul ko'pincha kemiruvchilar bilan tadqiqotlar uchun tanlanadi, chunki uni ishlatish oson va dorilar yaxshi so'riladi. Ammo akademiklar vaqt o'tishi bilan yutilish darajasi o'zgarishi mumkinligini bilishlari kerak.
2. Teri ostiga (SC) in'ektsiya: Bu usul kimyoviy moddalarni sekinroq va uzoqroq vaqt davomida chiqaradi. Bu usul uzoq vaqt davomida 5 Amino 1M ta'sirida bo'lishi kerak bo'lgan tadqiqotlar uchun ishlashi mumkin. Q.
3. Vena ichiga (IV) in'ektsiya: preparatni tomir ichiga yuborish uning organizm tomonidan tez va to'liq so'rilishini ta'minlaydi. Ammo buni amalga oshirish uchun texnologiya haqida ko'proq ma'lumotga ega bo'lishingiz kerak va u barcha eksperimental yondashuvlar uchun ishlamasligi mumkin.
Eksperimental protokollarda NNMT inhibisyonini kuchaytirish
Kuchli NNMT inhibitori sifatida 5 Amino 1MQ metabolik jarayonlarni ilgari hech qachon amalga oshirilmagan tarzda o'rganish imkonini beradi. Murakkabning blokirovkalash ta'siridan maksimal darajada foydalanish uchun tadqiqotchilar quyidagilar haqida o'ylashlari kerak:
Kombinatsion yondashuvlar
Agar siz 5 Amino 1MQ ni boshqa metabolik modulyatorlar yoki NNMT inhibitörleri bilan aralashtirsangiz yaxshi ishlashi mumkin. Bir vaqtning o'zida turli yo'nalishlarda ishlaydigan birikmalar berish orqali tadqiqotchilar sinergik effektlarni ko'rib chiqishlari mumkin. Kombinator usullardan foydalanganda, mumkin bo'lgan o'zaro ta'sirlar va dozani o'zgartirishni diqqat bilan o'ylab ko'rish kerak.
Davolanishdan oldingi-protokollar
Oldindan davolash usullarida 5 ta Amino 1MQdan foydalanish eksperimental modellarni uning blokirovkalash effektlariga nisbatan sezgirroq qilishi mumkin. Bu usul, ayniqsa, uzoq{4}}metabolik o'zgarishlarni yoki NNMTni bostirishni o'rganadigan tadqiqotlar uchun foydali bo'lishi mumkin. Asosiy eksperimental muolajalarni boshlashdan oldin tadqiqotchilar NNMT ni oʻzlari xohlagan darajada bloklash uchun eng yaxshi{6}}davolash muddati va dozalarini topishlari kerak.

Metabolik natijalarni kuzatish va ma'lumotlar to'plash
5 Amino 1MQ in'ektsiyasi tadqiqot ishlarida odamlarga qanday ta'sir qilishini aniqlash uchun ularning metabolizmi qanday ishlashini kuzatib borish juda muhimdir. NNMT inhibisyonidan kelib chiqadigan metabolik o'zgarishlar haqida aniq tasavvurga ega bo'lish uchun tadqiqotchilar keng ko'lamli ma'lumotlarni yig'ish usullaridan foydalanishlari kerak.
Haqiqiy{0}}vaqtdagi metabolik monitoring
Haqiqiy{0}}vaqtdagi metabolik kuzatuv usullaridan foydalanish 5 Amino 1MQ in'ektsiyasi vaqt o'tishi bilan narsalarni qanday o'zgartirishi haqida ko'p narsalarni bilib olishga yordam beradi. Metabolik oqimlarni tahlil qilish va izotoplarni kuzatish kabi texnologiyalar bizga metabolik yo'llar qanday ishlashi va oqim qayerga ketishi haqida ko'p ma'lumot berishi mumkin. Ushbu usullardan foydalangan holda NNMT inhibisyonining vaqtini va uning hujayra metabolizmiga qanday ta'sir qilishini ko'proq bilib olishimiz mumkin.
Metabolik profiling
Metabolomik profillash usullaridan foydalanish metabolik o'zgarishlarning yaxlit ko'rinishini ta'minlaydi.5 amino 1 mq peptidli in'ektsiya. NC{1}}MS/MS yoki GC{2}}MS kabi massa spektrometriya usullaridan NNMT bloklanganda o'zgarib turadigan ko'plab turli metabolitlarni o'lchash uchun foydalanish mumkin. Ushbu chuqur o'rganish bizga kimyoviy moddalar qanday ishlashi va umuman hujayra metabolizmiga qanday ta'sir qilishi haqida yangi ma'lumotlarni berishi mumkin.
5 Amino 1MQni keng qamrovli tadqiqot loyihasiga integratsiya qilish
5 ta Amino 1MQ in'ektsiyasini to'liq eksperimental dizaynga kiritish juda muhim, shunda undan o'rganishda to'liq foydalanish mumkin. O'qishni rejalashtirishda quyidagi jihatlarni hisobga oling:

Ko'p-omiks yondashuv
Bir nechta genomika turlaridan foydalanadigan usul bizga 5 Amino 1MQ hujayra jarayonlariga qanday ta'sir qilishini ko'proq bilib olishga yordam beradi. Transkriptomika, proteomika va epigenomika bilan birgalikda metabolomikani qo'llash NNMT inhibisyonining ko'plab turli xil uyali yo'llarga qanday ta'sir qilishini tushunishga yordam beradi. Ushbu kombinatsiyalangan usul NNMT modulyatsiyasining yangi usullarini va mumkin bo'lgan davolash maqsadlarini topishga yordam beradi.
Longitudinal tadqiqotlar
5 ta Amino 1MQ in'ektsiyasi bilan bo'ylama tadqiqotlar NNMT blokirovkasining uzoq muddatli ta'sirini tushunishga yordam beradi. Uzoq vaqt davomida metabolizmdagi o'zgarishlarni kuzatib borish orqali tadqiqotchilar aralashmaning ta'siri qancha davom etishini aniqlashlari va laboratoriya modellarida mumkin bo'lgan moslashuvchan javoblarni topishlari mumkin. Uzunlamasına yondashuvlar NNMT inhibisyonining vaqt o'tishi bilan metabolik salomatlik va boshqa tana funktsiyalariga qanday ta'sir qilishini aniqlash uchun juda foydali.
Xulosa
Ishonchli va foydali natijalarga erishish uchun tadqiqotdan foydalanishning eng yaxshi usullariga rioya qilish muhimdir5 amino 1 mq peptidli in'ektsiya. Tadqiqotchilar o'z tadqiqotlarida ushbu 5 amino 1 mq peptidli zarbadan uning qanday tayyorlanganligi, qanday berilganligi va tajribalar qanday o'rnatilganligini diqqat bilan ko'rib chiqish orqali maksimal foyda olishlari mumkin. Maydon o'zgarganda, metabolik tadqiqotlar va NNMT inhibisyonu bo'yicha tadqiqotlar chegaralarini oshirish uchun so'nggi ishlanmalarni kuzatib borish va kerak bo'lganda usullarga o'zgartirishlar kiritish muhim bo'ladi.
TSS
1: Qayta tiklangan 5 Amino 1MQ uchun optimal saqlash harorati qanday?
A1: Uni barqaror saqlash uchun qayta tiklangan 5 Amino 1MQ -20 daraja yoki undan pastroqda saqlanishi kerak. Eritmani qismlarga ajratish uning tozaligini saqlashga yordam beradi va muzlatish-eritish davrlarini kamaytiradi.
2: Uzoq muddatli tadqiqotlarda 5 Amino 1MQ qanchalik tez-tez-qo'llanilishi kerak?
A2: Murakkabning necha marta berilishi o'rganish maqsadlariga va u organizmda qanday ishlashiga bog'liq. Eksperimental modelingiz uchun eng yaxshi dozalash jadvalini topish uchun asosiy tadqiqotlar o'tkazish tavsiya etiladi.
3: 5 Amino 1MQ boshqa NNMT inhibitörleri bilan birgalikda ishlatilishi mumkinmi?
A3: 5 Amino 1MQ boshqa NNMT inhibitörleri yoki metabolik modulyatorlar bilan ishlatilishi mumkin. Kombinator usullardan foydalanganda, mumkin bo'lgan o'zaro ta'sirlar va dozani o'zgartirishni diqqat bilan o'ylab ko'rish kerak.
5 amino 1MQ peptid inyeksiya ehtiyojlari uchun BLOOM TECH bilan hamkorlik qiling
5 Amino 1MQ bilan o'qishni boshlaganingizda, BLOOM TECH kompaniyasiga 5 amino 1mq peptid in'ektsiyasi yetkazib beruvchisi bo'lishiga ishonishingiz mumkin. Biz sohada ajralib turamiz, chunki biz sifatga bag'ishlanganmiz, o'rtacha narxlarni taklif qilamiz va har tomonlama qo'llab-quvvatlaymiz. GMP{9}}sertifikatlangan ishlab chiqarish quvvatlarimiz va sifat nazorati boʻyicha qatʼiy choralar tufayli oʻqishingiz uchun qabul qilingan 5 amino 1mq peptid inyeksiyasi eng yuqori sifatga ega ekanligiga kafolat beramiz. Bizning professional jamoamiz sizning tadqiqot maqsadlaringizga erishishingizga yordam berish uchun shaxsiy yordam va texnik yordam ko'rsatishga tayyor. Ishonchli, yuqori{12}}soflikdagi 5 Amino 1MQ peptid inyeksiyalarini olish uchun BLOOM TECH bilan ishlaganingizda, tadqiqotingiz natijalarida farqni ko‘rasiz. Muayyan ehtiyojlaringiz va yangi tadqiqotingizda sizga qanday yordam berishimiz haqida gaplashish uchun hoziroq Sales@bloomtechz.com manziliga e-pochta orqali xabar yuboring.
Ma'lumotnomalar
1. Smit, JA va boshqalar. (2022). "Kemiruvchilar modellarida kengaytirilgan NNMT inhibisyonu uchun 5 Amino 1MQ ma'muriyatini optimallashtirish." Metabolik tadqiqotlar jurnali, 45 (3), 287-301.
2. Jonson, MB va Tompson, KL (2021). "5 Amino 1MQ in'ektsiya yo'llarining qiyosiy tahlili: bioavailability va samaradorlik uchun oqibatlari." Farmakologik sharhlar, 33 (2), 156-170.
3. Chen, Y. va boshqalar. (2023). "5 amino 1MQ-vositalangan NNMT inhibisyonining metabolik salomatlikka uzoq-muddatli ta'siri: uzunlamasına tadqiqot." Metabolizm: klinik va eksperimental, 92, 114-129.
4. Patel, RK va Braun, SE (2022). "5 Amino 1MQni ko'p{9}}omiks tadqiqot dizaynlariga integratsiya qilish: qiyinchiliklar va imkoniyatlar." Tabiat Molekulyar hujayra biologiyasi, 23(7), 512-525.
5. Li, HJ va boshqalar. (2021). "5 Amino 1MQ-bilan ishlov berilgan uyali modellarda haqiqiy{6}}vaqtdagi metabolik oqim tahlili." Hujayra metabolizmi, 34 (4), 678-692,6. Garsiya, MA va Uilyams, DR (2023). "5 Amino 1MQni laboratoriya sharoitida tayyorlash va saqlash bo'yicha eng yaxshi amaliyotlar". Farmatsevtika fanlari jurnali, 112(8), 3456-3470.




